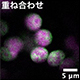

研究成果(プレスリリース)2023

2023年12月26日
B型肝炎の完治が見込まれる新たな抗ウイルス薬の候補を発見
2023年12月25日
周りを見て考えて手を動かす自動実験ロボ
2023年12月23日
「ポストコロナ」で警戒すべき心不全パンデミック
2023年12月22日
微小な識別子マテリアルの計算論的デザイン手法を開発
2023年12月20日
実験・計算・AIを融合した多結晶材料情報学によるマクロからナノへの材料解析手法を構築
2023年12月20日
感情次元に対応する表情データベースを開発
2023年12月20日
アンドレーエフ分子の観測・制御に成功
2023年12月20日
金触媒反応を引き金とするハイドロゲル化
2023年12月19日
シングルサイクルレーザー光の増幅法を開発
2023年12月19日
新型コロナウイルス排出と粘膜抗体の関係を解明
2023年12月15日
女性非喫煙者の食道がん発症に免疫が関与
2023年12月15日
ナノ半導体界面でのエネルギー共鳴現象を発見
2023年12月14日
特発性肺線維症の病態解明につながる新たなモデルマウスの開発
2023年12月14日
生体チオール検出ツールの最小化に成功
2023年12月14日
マウスは進化の過程で遺伝子治療薬として働くRNAを獲得していたことを解明
2023年12月14日
素子間の結合で異常ジョセフソン効果を創発

2023年12月12日
疾患の原因となる細胞間相互作用を見えるようにする蛍光技術
2023年12月12日
高効率な蛍光タンパク質導入法の開発
2023年12月11日
動物の触手は植物の葉と同じルールで配置される?
2023年12月8日
相変化メモリの高度化につながる、圧力下でのガラス相転移機構を解明
2023年12月6日
原子核の分子構造を発見
2023年12月5日
若いうちこそ「腹八分目」
2023年12月1日
単一コロイド量子ドットで電気伝導の評価と制御に成功
2023年12月1日
光回復酵素による損傷DNA修復反応を原子レベルで解明
2023年12月1日
蛍光タンパク質StayGoldの性能アップ
2023年11月30日
ヒューマノイドロボットは再生医療の現場へ
2023年11月29日
アトピー性皮膚炎のかゆみ伝達機序を解明
2023年11月28日
反強磁性状態における空間変調した超伝導状態の存在を予言
2023年11月27日
極超短パルス光を「光渦」に変換
2023年11月24日
トランジスタの新動作原理プラズモンでテラヘルツ波の検出感度を一桁以上高めることに成功
2023年11月24日
熱が引いても疲れが取れない理由
2023年11月24日
テレスコープアレイ実験史上最大のエネルギーをもつ宇宙線を検出
2023年11月22日
最重要MRIプローブであるピルビン酸の光を用いた高核偏極化に成功
2023年11月22日
tRNAの糖修飾がタンパク質合成速度を調節する
2023年11月22日
AI技術で新型コロナウイルスの進化メカニズムを分析
2023年11月21日
エイズウイルスが被膜を形成する機構を解明
2023年11月20日
焦点距離を変えられるメタレンズを開発
2023年11月15日
機械学習で屈折コントラストCTの高速領域分割解析を実現
2023年11月15日
植物の長期高温ストレス耐性には正確なmRNAスプライシングの維持が重要
2023年11月15日
必須遺伝子が染色体に無くても生物は絶滅しない
2023年11月14日
熱流によるスキルミオンとアンチスキルミオンの相互変換
2023年11月14日
脳予測に関わる誤差信号が高次聴覚野から一次聴覚野へフィードバックすることを発見
2023年11月13日
光合成微生物が形成するバイオフィルムの成分の非標識・超解像での可視化に成功
2023年11月10日
アスパラギン合成酵素を阻害するビサボスクアールAの発見

2023年11月9日
コヒーレントX線を用いた二つの計測手法の融合
2023年11月9日
隠された磁気を超音波で診断
2023年11月8日
非喫煙者に多いEGFR変異肺腺がんへのかかりやすさを解明
2023年11月7日
日本人の腸内微生物叢・ヒトゲノム・血中代謝物の関連が明らかに
2023年11月7日
ゴムと金属の接着老化に関わる反応の可視化に成功
2023年11月6日
ついに解明!超巨大ブラックホールの成長メカニズムと銀河中心の物質循環
2023年11月3日
植物の小胞体ストレス応答の遠隔伝達機構を解明
2023年11月1日
牛乳アレルギーの免疫寛容維持と腸内細菌叢の関連
2023年11月1日
新規ミトコンドリア膜貫通ペプチドによる遺伝子送達
2023年11月1日
単一の制御因子を用いて植物ステロイド成分蓄積の短期間での誘導に成功
2023年10月31日
過去最大規模の免疫フェノタイプ解析で自己免疫疾患の患者を層別化
2023年10月31日
本土と琉球列島における自然選択の痕跡
2023年10月31日
99%が水からできた固体なのに、水となじみにくい「ゲル・ゲル相分離材料」を発明
2023年10月30日
抗てんかん薬による薬疹の種類別リスク因子を発見
2023年10月30日
ナチュラルキラーT細胞の長期メモリー細胞への分化機構

2023年10月27日
AIでX線自由電子レーザー(SACLA)の輝度を大幅増
2023年10月26日
磁石によるうろこ模様で回る音波を制御
2023年10月25日
高核偏極化のための高性能な色素分子の開発に成功
2023年10月25日
睡眠制御における転写後プロセスの役割を解明
2023年10月25日
超伝導になる電子のカタチが見えた!量子ビームで描く次世代材料の設計図
2023年10月24日
ナノシートの配列制御によって構造色の重ね合わせに成功
2023年10月20日
室温で作動するH–導電性固体電解質の開発
2023年10月20日
クォーク4個から成る「純粋テトラクォーク」
2023年10月20日
アトピー性皮膚炎患者の個別化医療へ前進
2023年10月20日
カマキリを操るハリガネムシ遺伝子の驚くべき由来
2023年10月18日
窒素分子からヒドラジン誘導体作製に成功
2023年10月18日
X線回折に潜む非線形性の発見
2023年10月17日
エピゲノム修飾の位置を端から数える仕組み
2023年10月16日
膵臓がんを画像で描出し、アルファ線で攻撃
2023年10月12日
共生菌に栄養を依存するラン(蘭)の発芽メカニズムを解明
2023年10月11日
結晶の“ズレ”が音速を超えて伝播することを実証
2023年10月11日
国宝油滴天目茶碗の曜変(光彩)の秘密を探る
2023年10月10日
シリコン量子ビット間で強い誤り相関を観測
2023年10月5日
新型コロナウイルス感染によるクラスター発生確率の計算に成功
2023年10月4日
卵巣がんの発がんメカニズムを解明
2023年10月4日
自由電子レーザーにおける「光のすり抜け現象」制御に成功
2023年10月3日
遺伝子発現を活性化するスーパーエンハンサーの再定義
2023年10月2日
ありふれた脳の白質病変がMRI画像解析を悪化させていた
2023年9月27日
極微量の触媒で抗がん剤を体内で大量生産
2023年9月27日
キラーT細胞を活性化するRNAワクチンを創出
2023年9月27日
ドーパミン細胞が匂いの価値を表現し更新する機構を解明
2023年9月26日
大量の回折データから異なる構造情報を見いだす方法
2023年9月26日
干ばつがパンコムギ種子に及ぼす分子的影響の解明
2023年9月22日
放射光X線が地球核の化学組成を変える
2023年9月21日
電子伝導性と製造プロセス性のいいとこ取り!
2023年9月20日
中性子結晶構造解析によって酵素ラジカル反応中間体の詳細構造を初めて解明
2023年9月19日
レーザー融解によるアイスコアの微細試料採取装置の開発
2023年9月19日
温度による酵素の構造変化を分子動画撮影
2023年9月15日
細胞外小胞の軌跡を照らす
2023年9月8日
生体深部を非侵襲的に観察できる多色発光イメージング用マウス
2023年9月7日
スキルミオンによるトポロジカル磁気光学効果の観測に成功
2023年9月4日
アポトーシス抵抗性細胞の細胞死
2023年9月4日
細胞シートを3次元に折れたたむ仕組み発見

2023年9月1日
オンライン生成不安定原子核の電子散乱に初めて成功
2023年8月31日
肺線維症発症の中心的機構を発見
2023年8月31日
人工元素アスタチンの大量製造法を開発
2023年8月31日
極限原子核の謎を解く要となる新たな酸素同位体の発見
2023年8月31日
インスリン抵抗性に関連するヒト腸内細菌の網羅的解析
2023年8月29日
ヒスチジン残基のpiメチル化修飾によるRNA代謝調節
2023年8月29日
植物成長促進ホルモンの新たな活性化経路を発見
2023年8月28日
脳心筋炎ウイルスはRNAの動的構造平衡を利用して増える
2023年8月25日
植物細胞の小胞体をストレスから守る新たな因子の働き
2023年8月24日
酵素活性を最大化する理論的な条件の発見
2023年8月23日
生きたES細胞で転写因子の機能を分子精度で定量
2023年8月23日
ポリジェニックリスクスコアで前立腺がんの死亡リスクを予測
2023年8月23日
異常な「4価の鉄」の酸化物の謎を解明
2023年8月21日
水電解における水素発生の高効率化を実現
2023年8月19日
レチノイン酸受容体の新たな構造体を細胞質で発見
2023年8月18日
寒さに強いマウスは、細胞も寒さに強い
2023年8月17日
ソバゲノムの解読
2023年8月11日
X染色体不活化の安定性は染色体の形が鍵だった
2023年8月7日
培養神経回路において自由エネルギー原理を実証
2023年8月4日
新たな生体リズムを毛の形態形成モデルから解明
2023年8月1日
電子の波動関数操作によりピコ秒以下の超高速で磁化制御を実現
2023年8月1日
シングルセルRNA-seqデータから細胞種を同定する深層学習
2023年8月1日
素子間の結合により超伝導ダイオードを実現
2023年7月31日
新型コロナウイルスパパイン様プロテアーゼの構造柔軟性
2023年7月27日
蛍光X線スペクトルの2次元化に成功
2023年7月25日
パラジウム錯体でβ-ケトアミド修飾ペプチドを捕捉
2023年7月25日
2次元トポロジカル絶縁体を使ったジョセフソン接合
2023年7月24日
世界最高速で試料回転を行う固体NMRプローブを開発
2023年7月21日
光スイッチ型蛍光タンパク質の反応を可視化
2023年7月21日
デングウイルスのRNA複製酵素の立体構造を解明
2023年7月20日
肺に存在する新たな幹細胞の発見
2023年7月19日
充放電による蓄電池電極劣化の経時的進行を3次元でとらえる新技術を開発
2023年7月19日
指定難病 間質性膀胱炎(ハンナ型)の遺伝的背景を解明
2023年7月19日
多彩な電子相を示す有機化合物の物理特性を支配する重要パラメータの特定に成功
2023年7月18日
脊柱後縦靭帯骨化症の発症原因の一端を解明
2023年7月17日
遺伝子発現を制御するエピゲノムの複製と転写
2023年7月14日
これまでの高温超伝導体は乱れていたことが判明
2023年7月12日
「掛け算」のできる光量子コンピュータへ
2023年7月12日
自然が見出していない未踏のタンパク質トポロジー
2023年7月11日
ショウジョウバエ原腸胚における1細胞遺伝子発現アトラスを作成
2023年7月11日
脂肪酸合成を阻害する新たな抗真菌化合物の発見
2023年7月10日
アンモニアを貯蔵するペロブスカイト化合物
2023年7月10日
シチズンサイエンスで挑む雷の謎

2023年7月7日
染色体のフラクタルな超構造を可視化
2023年7月6日
特殊なデンプンでナトリウムを吸着・無害化するヒナアズキ
2023年7月3日
がんに対するaAVCワクチンとIL-2の併用療法を開発
2023年7月3日
鉄欠乏条件で誘導するフィコビリソームと光化学系I複合体の強固な結合
2023年7月3日
クマバチから補酵素NADの合成能を欠損する自力では生育できない乳酸菌を発見
2023年7月3日
世界最小のコイル状バネを設計し、細胞への“微小な力”の計測に成功
2023年6月30日
さまざまな種類のがんの発症に関わる遺伝子を明らかに
2023年6月30日
超伝導量子コンピュータにおける新しい2量子ビットゲート方式の発明・実証
2023年6月30日
最前線で胃を守れ
2023年6月27日
わずか窒素3原子でがんを見つけてα線治療
2023年6月22日
陽子内のグルーオンのスピンの向きを決定
2023年6月21日
「富岳」実装版「OpenFold」の提供開始
2023年6月20日
バイオマス増加をもたらすF1雑種における代謝物の変化を解明
2023年6月20日
思春期特発性側弯症の発症の遺伝的な因果関係を発見
2023年6月19日
極端現象の制御シミュレーション実験
2023年6月19日
異なる二次元結晶を重ねた界面でスピン偏極した光電流が流れることを発見
2023年6月15日
ストレスに適応する植物たち
2023年6月15日
脳動脈瘤発生に重要な体細胞遺伝子変異を発見
2023年6月14日
ヒストンH3タンパク質のクロトニル化修飾により大腸がん細胞が増幅する仕組みを解明
2023年6月13日
肝がん再発予防薬の標的タンパク質を同定
2023年6月12日
世界最速・簡易遺伝子検査法「Direct-SATORI法」の開発
2023年6月10日
巨大スパインに基づく統合失調症の病態生理の新仮説
2023年6月9日
肺腺がんリスクを決める遺伝子の個人差を同定
2023年6月8日
血液の分解産物ビリルビンが植物で作られることを発見
2023年6月6日
AIで早期胃がんの範囲診断が可能に
2023年6月5日
塩害から種子形成を保護するナトリウム輸送体

2023年6月2日
閉経期マウスの生殖中枢イメージング
2023年6月1日
シリコン量子ビットのフィードバック型初期化技術を開発
2023年5月31日
クライオ電顕により電荷、水素原子、化学結合を可視化
2023年5月31日
神経幹細胞の活性状態と休眠状態を制御する仕組み
2023年5月31日
擬似的なヒト腸内細菌群集を作製し様々な解析手法を評価
2023年5月30日
パーキンソン病や認知症の原因タンパク質が血液検査で検出可能に
2023年5月30日
双極性障害の病態解明につながるモザイク変異・ミトコンドリア変異の同定
2023年5月26日
個体を傷付けず、生きた心筋活性を光で定量
2023年5月26日
高移動度の半導体コロイド量子ドット超格子を実現
2023年5月26日
柔軟なエピゲノムがクロマチン構造を維持する
2023年5月26日
消えるのか?残るのか?
2023年5月26日
結晶の写真からAIにより結晶粒方位分布を予測
2023年5月25日
複数のねじれを持つ芳香族ベルト分子の合成に成功
2023年5月23日
母マウスのオキシトシン神経活動を簡便に記録
2023年5月22日
固体触媒を用いたフロー型カップリング反応システム
2023年5月19日
腎臓がんの自然史を国際共同研究により解明
2023年5月19日
腸内微生物叢シークエンシングデータ中に存在するヒトゲノム由来配列からの個人情報の再構築
2023年5月19日
高精度の構造多型検出手法を開発
2023年5月17日
オルガノイド由来細胞を用いた腎近位尿細管モデルチップを開発
2023年5月17日
カエル胚がお尻の穴を開く仕組み
2023年5月17日
マーモセットの前頭前野結合マップを作成・公開
2023年5月16日
がん悪液質に関わるがん細胞分泌タンパク質の発見
2023年5月16日
新規ミトコンドリア分裂因子を発見
2023年5月12日
転移因子多型の疾患リスクを解明
2023年5月10日
授乳期の短鎖脂肪酸が子の気管支喘息を改善する
2023年5月10日
量子電磁力学をエキゾチック原子で検証
2023年5月9日
なぜひとは誤情報を信じ続けるのか?
2023年4月28日
抗菌薬に依存しない仔牛の飼養管理
2023年4月27日
MRIによる霊長類のデジタル脳データベースを開発
2023年4月27日
量子力学世界を「スケール分離」する
2023年4月27日
長鎖遺伝子間非翻訳RNAの組織特異的発現の礎となる染色体トポロジカルドメイン
2023年4月26日
タンパク質合成に関わる新たな因子を発見
2023年4月25日
COVID-19重症化における自然免疫細胞の関わりを明らかに
2023年4月24日
横紋筋特異的なリボソームを発見
2023年4月21日
超伝導の最適化:精密転移温度評価理論に基づく、新高温超伝導物質の予言
2023年4月21日
反強磁性体におけるトポロジカルホール効果の実証に成功
2023年4月19日
酵素発現領域を染め分ける高感度ラマンプローブの開発
2023年4月17日
重症拡張型心筋症の病態を解明し新たな治療標的を同定
2023年4月17日
グラフが論理的思考力を高める
2023年4月17日
リジン長鎖アシル化による新規転写制御機構の発見
2023年4月14日
エントロピー増大に逆らうゲル材料
2023年4月12日
持続可能な農業のための堆肥-土壌-植物相互作用モデル
2023年4月11日
フェムト秒レーザーGHzバーストモードアブレーション
2023年4月10日
X線自由電子レーザーで捉えたビフィズス菌酵素の常温構造
2023年4月6日
転写が盛んなゲノム領域も「塊」を作っていた!
2023年4月3日
後縦靭帯骨化症の原因遺伝子を発見
2023年4月3日
40年ぶりに中性子過剰なウラン同位体を新発見
2023年3月31日
高CO2環境でイネを増収させる「コシヒカリ」由来の遺伝子を発見
2023年3月30日
プリオン様ドメインがストレス下でもマウスの不快記憶形成を可能にすることを発見
2023年3月30日
遺伝要因がピロリ菌感染の胃がんリスクを高めることを解明
2023年3月29日
VRシステムによる神経ネットワーク動態の可視化
2023年3月28日
卵で増えない胎生のサメも卵黄遺伝子を持つ
2023年3月27日
“π”で探る真空の秘密
2023年3月24日
ミニ臓器に体軸方向を与える技術を開発
2023年3月23日
ジンベエザメだけに起きた視覚の進化
2023年3月23日
視覚に関わるタンパク質の超高速分子動画
2023年3月21日
XFELと電子顕微鏡による低分子有機化合物の結晶構造解析
2023年3月17日
母親からのゲノムに“刷り込まれる”記憶の多様性
2023年3月16日
生体から発想を得た分子スケールの水輸送方法の提案
2023年3月16日
SPring-8で糖尿病進行に伴う鉄・亜鉛の変動を解明
2023年3月14日
椎間板と内耳を作る組織に特有の細胞外物質
2023年3月14日
極めて複雑な合成医薬分子に短寿命核種を導入
2023年3月14日
STING炎症シグナルの終結分子機構
2023年3月14日
リボソーム品質管理の破綻と神経疾患
2023年3月9日
ウイルス由来ゲノムが自閉症に関わる?
2023年3月7日
極微小バルブで1分子の流れの制御に成功
2023年3月7日
超高速量子計算のための世界最速43GHzリアルタイム量子信号測定に成功
2023年3月3日
異常金属における超低速臨界電子電荷ゆらぎの観測に成功
2023年3月3日
タンパク質の凝縮を制御する分子機構
2023年3月2日
熱流注入で磁気を観る
2023年3月2日
狙った物性を示す物質を自動設計する理論手法を開発
2023年3月2日
水を高核偏極化する色素材料の開発に成功
2023年2月28日
翻訳阻害剤を介した、植物と糸状菌間の生存競争
2023年2月28日
植物の器官再生を制御する酵素を発見
2023年2月27日
原発性アルドステロン症の発症に関わる遺伝子を同定
2023年2月22日
地球温暖化に伴う超高層大気の収縮をX線天文衛星で解明
2023年2月22日
タンパク質の水和構造を予測する人工知能
2023年2月21日
シアノバクテリアの光化学系I単量体IsiA超複合体の立体構造解明
2023年2月21日
双極性障害の躁・うつの両方の症状を示す世界初の動物モデルの作製に成功
2023年2月17日
細胞内の小さな異変をキャッチ
2023年2月16日
肝細胞分化の詳細なオミックスデータを公開
2023年2月15日
溶質と溶媒が相互に影響し合う機構を原子レベルで直接観測
2023年2月14日
一酸化窒素はDNA修飾の制御因子であることを発見
2023年2月9日
遺伝子の読み取りを終わらせるメカニズム
2023年2月2日
細胞死を引き起こすサヨナラ遺伝子
2023年2月1日
植物油脂の合成には葉緑体と小胞体の酵素が協調して働く
2023年1月31日
培養ゲルを適材適所に
2023年1月30日
ユーグレナの眼点をつかさどる色素を同定
2023年1月30日
世界初!AIが描く天の川銀河のガス雲分布
2023年1月27日
K中間子と陽子が織りなす風変わりなバリオンを測定
2023年1月26日
老化T細胞が老化・炎症を引き起こす仕組みを解明
2023年1月24日
多価イオンの新分光法を実証
2023年1月23日
グルコシノレート分解酵素の液胞への輸送を可視化
2023年1月20日
光受容によるリボソーム生合成関連遺伝子の翻訳活性機構
2023年1月20日
トポロジカル絶縁体で電気磁気効果を初めて観測
2023年1月19日
心房細動の遺伝的基盤を解明
2023年1月18日
悪玉脂質を産生する腸内細菌が肥満を悪化させる
2023年1月17日
自然免疫受容体TLR3が多量体を形成して二本鎖RNAに結合した構造を解明
2023年1月16日
未知の転写・転写後制御を解明
2023年1月13日
X染色体不活性化の維持のメカニズムを解明
2023年1月12日
鎌状赤血球症の新しい治療薬候補を開発
2023年1月12日
ブルーカーボンのための海草底泥の共生環境を予測
2023年1月12日
体づくりの左右非対称性を決める「力」の発見
2023年1月12日
睡眠中の脳の学習理論
2023年1月11日
反応途中の酵素を観る新手法の開発
2023年1月11日
超小型「光周波数のものさし」の精密制御を実証
2023年1月10日
光合成が始まる瞬間の代謝機構を解明
2023年1月6日
チタン・バナジウム中性子過剰同位体で新魔法数の消失を観測
2023年1月6日
タンデム触媒による新しいC-H官能基化反応の開発に成功
